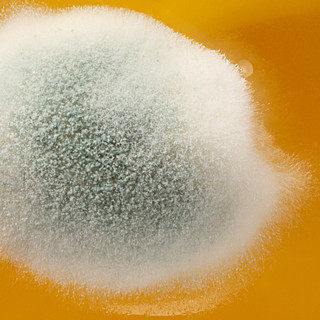
Какую плесень можно есть

Можно ли повторно замораживать продукты
И если да — то какие? Отвечает повар Александр Волков-Медведев
Почему надо печь при температуре 180 градусов
Рассказывают педагоги Школы «Еды» — Виталий Тихонов и Александр Кожанов
Что такое лектины и почему они стали новым глютеном
Разбираемся в убойной силе фасоли и помидоров вместе с нутрициологом
Польза орехов: миф или реальность
Из чего они на самом деле состоят и когда и в каком количестве их нужно есть
Чем фрукты отличаются от овощей
И почему на самом деле их не существует — подробный ответ директора ботанического сада биофака МГУ